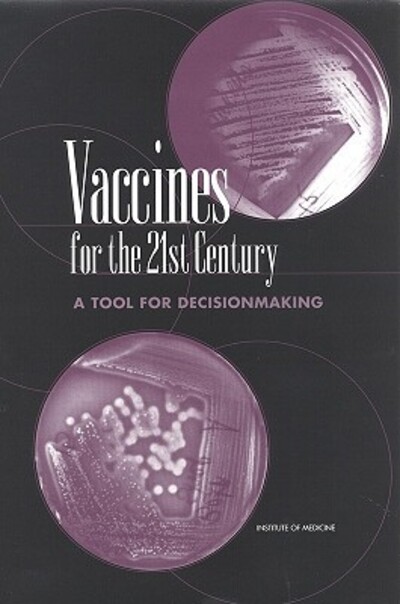

Currently Out Of Stock
Vaccines for the 21st century
Hardback
€157.20
Collect 471 Reward Points
- Currently Out Of Stock
- Book Synopsis
- Vaccines have made it possible to eradicate the scourge of smallpox, promise the same for polio, and have profoundly reduced the threat posed by other diseases such as whooping cough, measles, and meningitis. What is next? There are many pathogens, autoimmune diseases, and cancers that may be promising targets for vaccine research and development. This volume provides an analytic framework and quantitative model for evaluating disease conditions that can be applied by those setting priorities for vaccine development over the coming decades. The committee describes an approach for comparing potential new vaccines based on their impact on morbidity and mortality and on the costs of both health care and vaccine development. The book examines: lessons to be learned from the polio experience; scientific advances that set the stage for new vaccines; factors that affect how vaccines are used in the population; value judgments and ethical questions raised by comparison of health needs and benefits. The committee provides a way to compare different forms of illness and set vaccine priorities without assigning a monetary value to lives.;Their recommendations will be important to anyone involved in science policy and public health planning: policymakers, regulators, health care providers, vaccine manufacturers, and researchers.
- Product Details
-
- ISBN
- 9780309056465
- Format
- Hardback
- Publisher
- National Academy Press, (21 February 2001)
- Number of Pages
- 460
- Weight
- 934 grams
- Language
- English
- Dimensions
- 229 x 152 x 35 mm
- Categories: